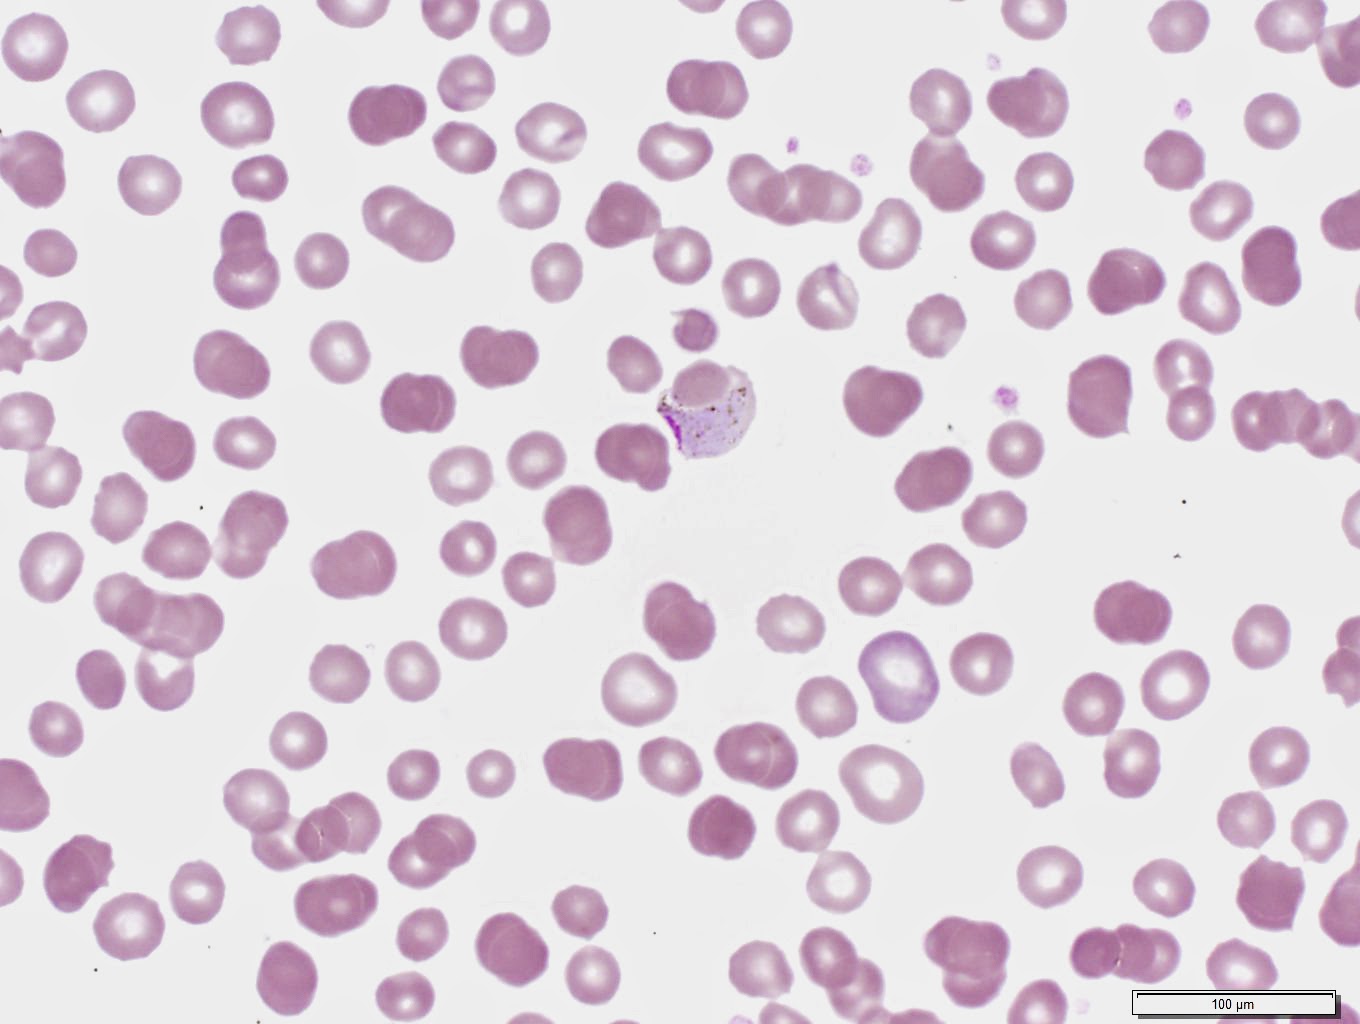

I'd like to first thank This Week in Parasitism and the hosts, Vincent Racaniello and Dickson Despommier for featuring my blog as their 75th podcast. You can hear the podcast HERE. Please check out their other podcasts - they're fun and contain great information!
Now for our case this week: A peripheral blood thin film from a patient with recurring fevers and recent travel to India. Identification?

10 comments:
hmmm, let me take a random guess - are these red blood cells infected w/malaria?
P. vivax most likely, probably fairly chronic with ring forms, a schizont and possibly a gametocyte.
Infected red cells are larger than surrounding non infected red cells. Somewhat small rings, some with double nuclei. Schizonts with more than 8 nuclei. Possibly gametocytes present. Infected red cell cave in at contact areas with adjacent cells.
All the findings are consistent with P. vivax.
Florida Fan
Plasmodium vivax.
Nice schizont with 16 merozoïds.
Hans Naus
Plasmodium vivax, some nice extra-cellular merozoites!
Lee
P. vivax. Nice
P.vivax definitely
P.vivax definitely
P vivax ring form, schizonts
Plasmodium vivax. Ring form, schizont and gametocytes seen.
Wan Hafiz
Post a Comment